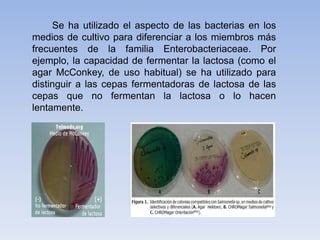
Se ha utilizado el aspecto de las bacterias en los
medios de cultivo para diferenciar a los miembros más
frecuentes de la familia Enterobacteriaceae. Por
ejemplo, la capacidad de fermentar la lactosa (como el
agar McConkey, de uso habitual) se ha utilizado para
distinguir a las cepas fermentadoras de lactosa de las
cepas que no fermentan la lactosa o lo hacen
lentamente.

1) Las salmonelas son bacterias gramnegativas que habitan en el tracto digestivo de mamíferos, aves y reptiles. 2) Poseen endotoxinas potentes pero no exotoxinas y son destruidas por la pasteurización o al exponerse a 60°C por 15-20 minutos. 3) Pueden causar infecciones como gastroenteritis o fiebre tifoidea al consumir alimentos o agua contaminados.